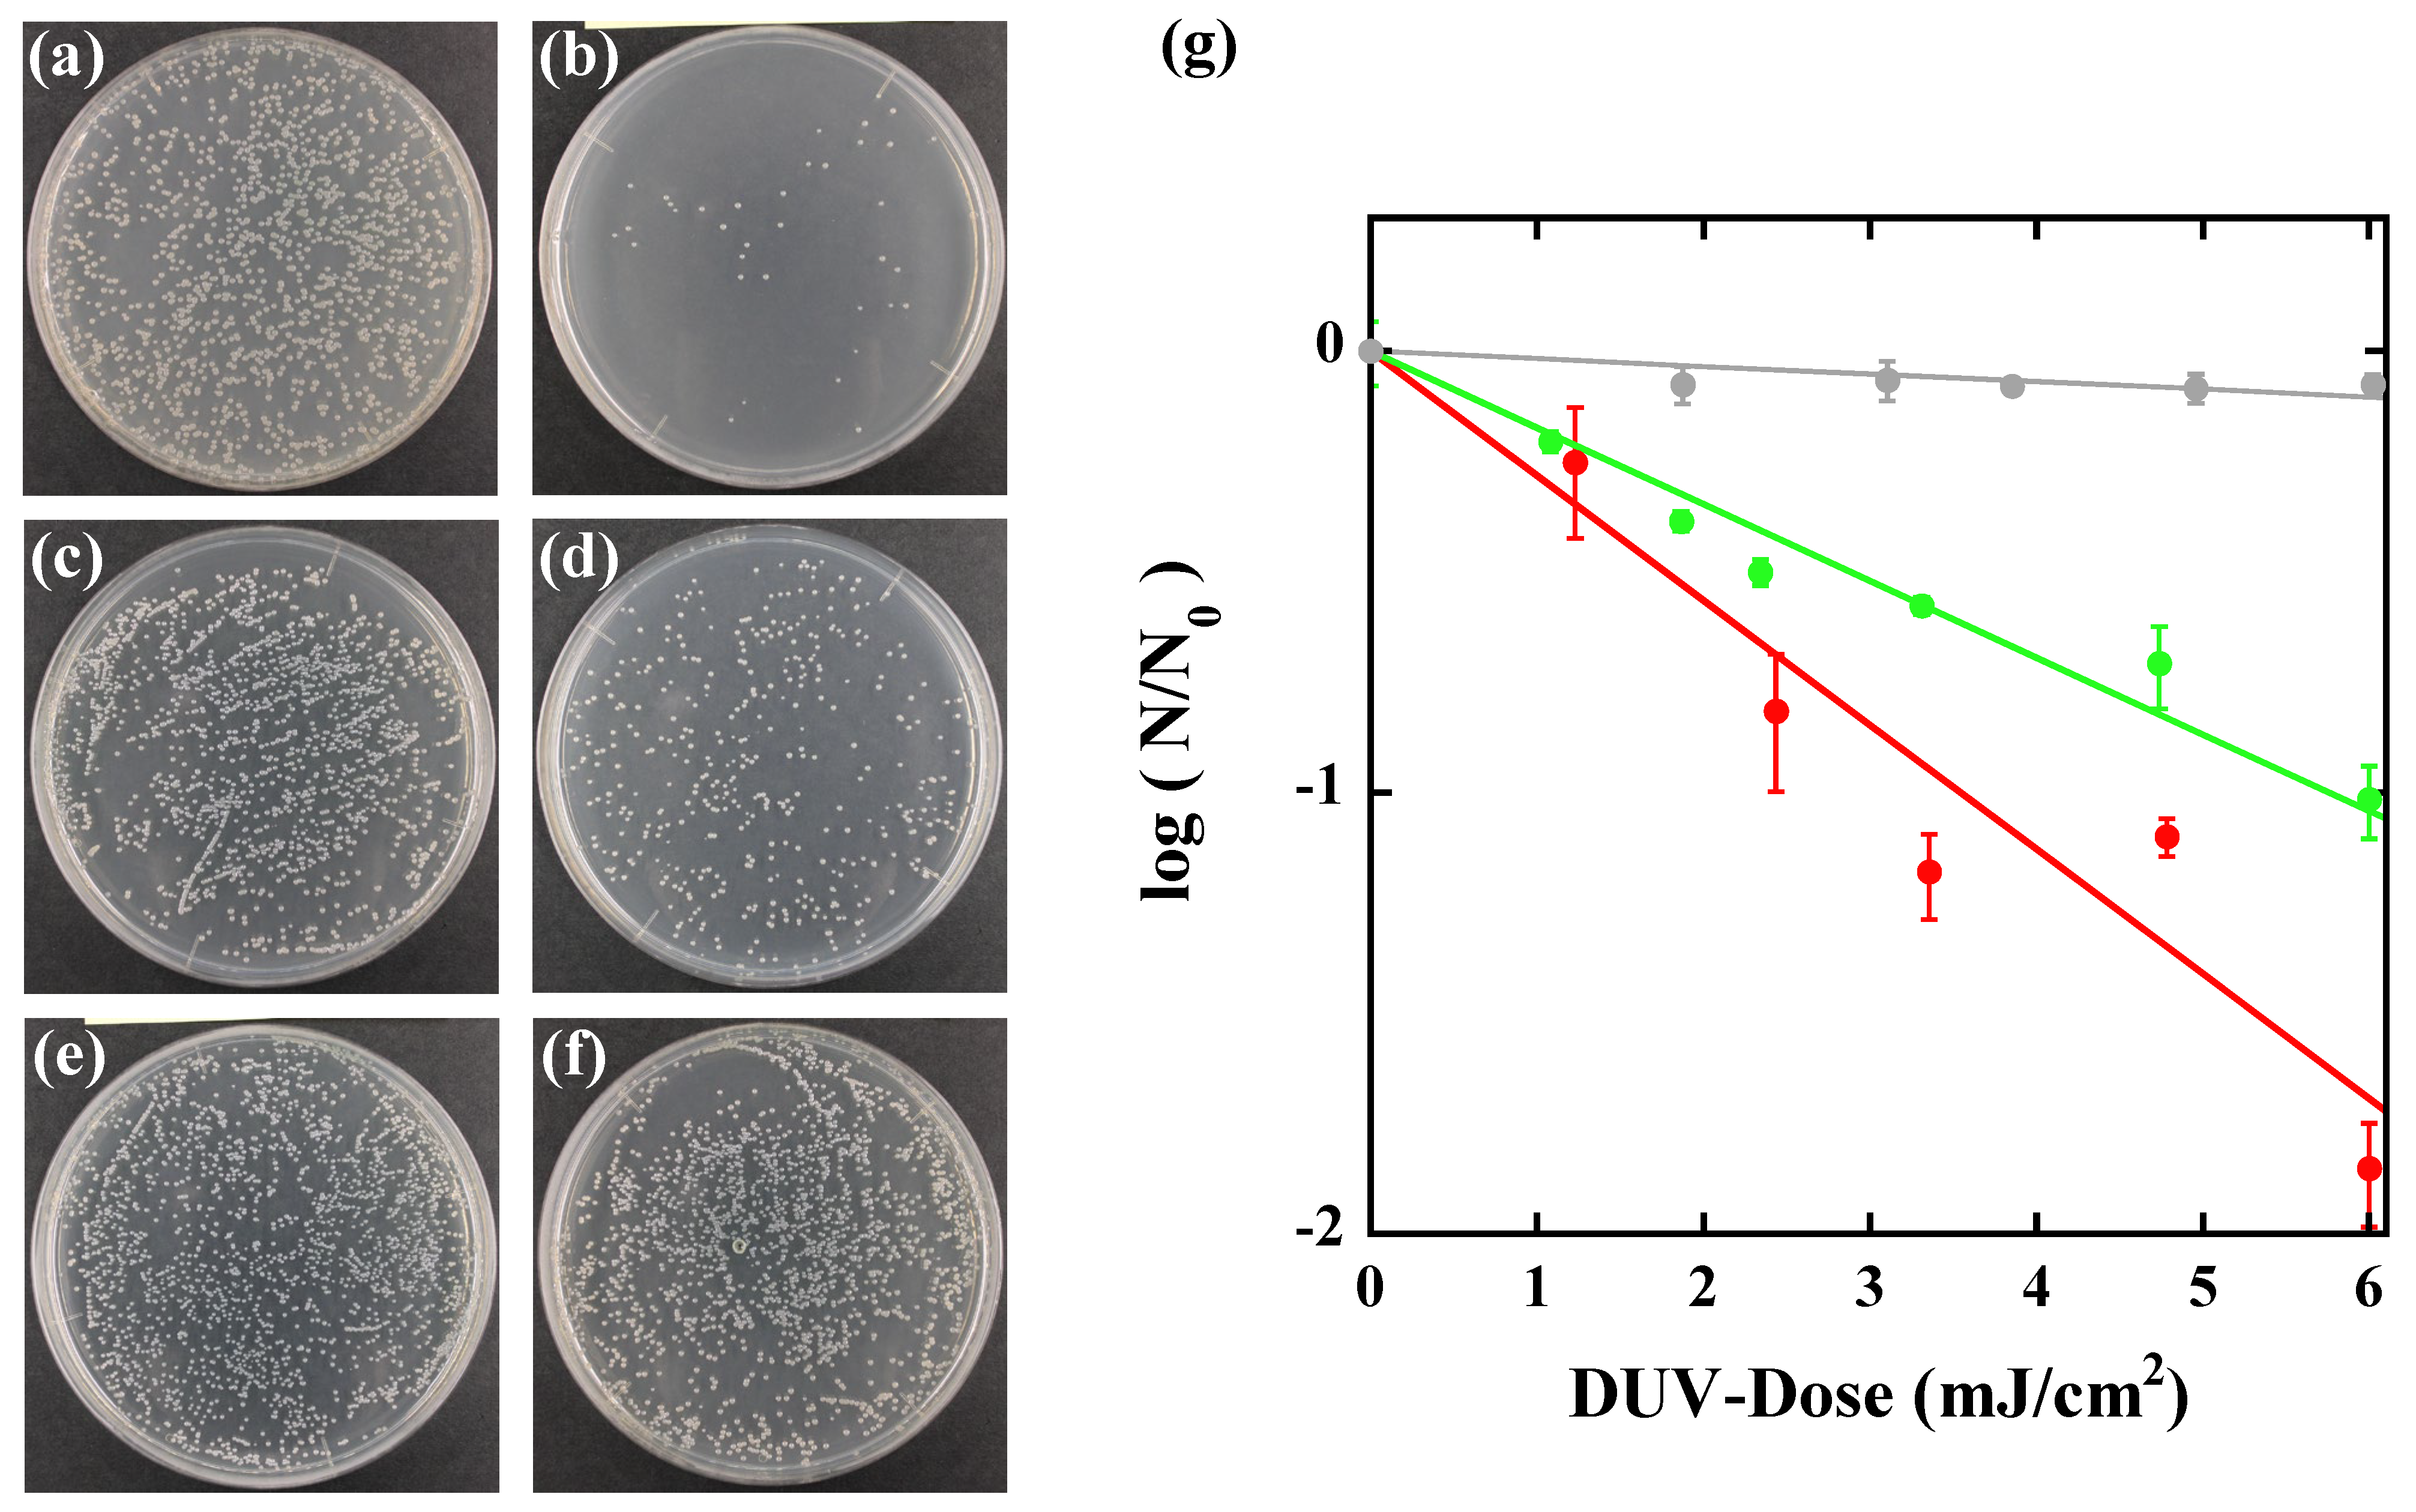
Water 14 01394 g005 550

Action Spectra of Bacteria and Purification of Pollutant Water at Faucets Using a Water Waveguide Method
Abstract
:1. Introduction
2. Materials and Methods
2.1. Culturing and Enumeration of Bacteria
2.2. Absorbance Measurements
2.3. Wavelength-Tunable DUV Light Source
2.4. Water Waveguide Disinfection System
3. Results
3.1. Wavelength-Dependent Inactivation Rate Constant for Various Bacteria Using the Wavelength-Tunable DUV Light Source: Microplate Experiments
3.2. Disinfection of Bacteria by Water Waveguide Methods: Water Purification Experiments
3.2.1. E. coli O1
3.2.2. P. aeruginosa
4. Discussion
5. Conclusions
Author Contributions
Funding
Institutional Review Board Statement
Informed Consent Statement
Acknowledgments
Conflicts of Interest
References
- Mac Kenzie, W.R.; Hoxie, N.J.; Proctor, M.E.; Gradus, M.S.; Blair, K.A.; Peterson, D.E.; Kazmierczak, J.J.; Addiss, D.G.; Fox, K.R.; Rose, J.B.; et al. A Massive Outbreak in Milwaukee of Cryptosporidium Infection Transmitted through the Public Water Supply. N. Engl. J. Med. 1994, 331, 161–167. [Google Scholar] [CrossRef] [PubMed]
- Corso, P.S.; Kramer, M.H.; Blair, K.A.; Addiss, D.G.; Davis, J.P.; Haddix, A.C. Costs of Illness in the 1993 Waterborne Cryptosporidium Outbreak, Milwaukee, Wisconsin. Emerg. Infect. Dis. 2003, 9, 426–431. [Google Scholar] [CrossRef] [PubMed]
- Stein, P.L. The Great Sydney Water Crisis of 1998. In Environmental Challenges; Belkin, S., Ed.; Springer: Dordrecht, The Netherlands, 2000. [Google Scholar] [CrossRef]
- Song, K.; Mohseni, M.; Taghipour, F. Application of ultraviolet light-emitting diodes (UV-LEDs) for water disinfection: A review. Water Res. 2016, 94, 341–349. [Google Scholar] [CrossRef] [PubMed]
- Lui, G.Y.; Roser, D.; Corkish, R.; Ashbolt, N.J.; Stuetz, R. Point-of-use water disinfection using ultraviolet and visible light-emitting diodes. Sci. Total Environ. 2016, 553, 626–635. [Google Scholar] [CrossRef]
- Chen, J.; Loeb, S.; Kim, J.H. LED revolution: Fundamentals and prospects for UV disinfection applications. Environ. Sci. Water Res. Technol. 2017, 3, 188–202. [Google Scholar] [CrossRef]
- Shah, J.; Židonis, A.; Aggidis, G. State of the art of UV water treatment technologies and hydraulic design optimisation using computational modelling. J. Water Process Eng. 2021, 41, 102367. [Google Scholar] [CrossRef]
- Matsumoto, T.; Kikojima, R.; Fukuoka, T.; Tatsuno, I.; Hasegawa, T. Total internal reflection of deep-ultraviolet light in a water waveguide and its application to water disinfection technologies. Water 2019, 11, 294. [Google Scholar] [CrossRef] [Green Version]
- Matsumoto, T.; Tatsuno, I.; Hasegawa, T. Instantaneous water purification by deep ultraviolet light in water waveguide: Escherichia coli bacteria disinfection. Water 2019, 11, 968. [Google Scholar] [CrossRef] [Green Version]
- Beaven, G.H.; Holiday, E.R.; Johnson, E.A. Optical properties of nucleic acids and their components. In The Nucleic Acids; Chargaff, E., Davidson, J.N., Eds.; Academic Press: New York, NY, USA, 1954; Volume 1, pp. 493–553. [Google Scholar]
- Rauth, A.M. The physical state of viral nucleic acid and the sensitivity of viruses to ultraviolet light. Biophys. J. 1965, 5, 257–273. [Google Scholar] [CrossRef] [Green Version]
- Meulemans, C.C.E. The basic principles of UV–disinfection of water. Ozone Sci. Eng. 1987, 9, 299–313. [Google Scholar] [CrossRef]
- Beck, S.E.; Wright, H.B.; Hargy, T.M.; Larason, T.C.; Linden, K.G. Action spectra for validation of pathogen disinfection in medium-pressure ultraviolet (UV) systems. Water Res. 2015, 70, 27–37. [Google Scholar] [CrossRef] [PubMed]
- Chan, H.L.; Gaffney, P.R.; Waterfield, M.D.; Anderle, H.; Matthiessen, P.; Schwarz, H.P.; Turecek, P.L.; Timms, J.F. Proteomic analysis of UVC irradiation-induced damage of plasma proteins: Serum amyloid P component as a major target of photolysis. FEBS Lett. 2006, 580, 3229–3236. [Google Scholar] [CrossRef] [PubMed]
- Verhaar, R.; Dekkers, D.W.C.; De Cuyper, I.M.; Ginsberg, M.H.; de Korte, D.; Verhoeven, A.J. UV-C irradiation disrupts platelet surface disulfide bonds and activates the platelet integrin αIIbβ3. Blood 2008, 112, 4935–4939. [Google Scholar] [CrossRef] [PubMed] [Green Version]
- Welch, D.; Buonanno, M.; Grilj, V.; Shuryak, I.; Crickmore, C.; Bigelow, A.W.; Randers-Pehrson, G.; Johnson, G.W.; Brenner, D.J. Far-UVC light: A new tool to control the spread of airborne-mediated microbial diseases. Sci. Rep. 2018, 8, 2752. [Google Scholar] [CrossRef] [PubMed] [Green Version]
- Buonanno, M.; Welch, D.; Shuryak, I.; Brenner, D.J. Far-UVC light (222 nm) efficiently and safely inactivates airborne human coronaviruses. Sci. Rep. 2020, 10, 10285. [Google Scholar] [CrossRef] [PubMed]
- Narita, K.; Asano, K.; Naito, K.; Ohashi, H.; Sasaki, M.; Morimoto, Y.; Igarashi, T.; Nakane, A. 222-nm UVC inactivates a wide spectrum of microbial pathogens. J. Hosp. Infect. 2020, 105, 459–467. [Google Scholar] [CrossRef]
- Narita, K.; Asano, M.; Morimoto, Y.; Igarashi, T.; Nakane, A. Chronic irradiation with 222-nm UVC light induces neither DNA damage nor epidermal lesions in mouse skin, even at high doses. PLoS ONE 2018, 13, e0201259. [Google Scholar] [CrossRef]
- Yamano, N.; Kunisada, M.; Kaidzu, S.; Sugihara, K.; Nishiaki-Sawada, A.; Ohashi, H.; Yoshida, A.; Igarashi, T.; Ohira, A.; Tanito, M.; et al. Long-term Effects of 222-nm ultraviolet radiation C Sterilizing Lamps on Mice Susceptible to Ultraviolet Radiation. Photochem. Photobiol. 2020, 96, 853–862. [Google Scholar] [CrossRef] [Green Version]
- Hunt, H.D.; Simpson, W.T. Spectra of Simple Amides in the Vacuum Ultraviolet. J. Am. Chem. Soc. 1953, 75, 4540–4543. [Google Scholar] [CrossRef]
- Rosenheck, K.; Doty, P. The far ultraviolet absorption spectra of polypeptide and protein solutions and their dependence on conformation. Proc. Natl. Acad. Sci. USA 1961, 47, 1775–1785. [Google Scholar] [CrossRef] [Green Version]
- Wetlaufer, D.B. Ultraviolet spectra Of Proteins and Amino Acids. Adv. Protein Chem. 1963, 17, 303–390. [Google Scholar]
- Ham, J.S.; Platt, J.R. Far U.V. Spectra of Peptides. J. Chem. Phys. 1952, 20, 335. [Google Scholar] [CrossRef]
- Hall, J.D.; Mount, D.W. Mechanisms of DNA replication and mutagenesis in ultraviolet-irradiated bacteria and mammalian cells. Prog. Nucleic Acid Res. Mol. Biol. 1981, 25, 53–126. [Google Scholar] [PubMed]
- Sutherland, B.M.; Shih, A.G. Quantitation of pyrimidine dimer contents of nonradioactive deoxyribonucleic acid by electrophoresis in alkaline agarose gels. Biochemistry 1983, 22, 745–749. [Google Scholar] [CrossRef] [PubMed]
- Friedberg, E.C.; Walker, G.C.; Siede, W. DNA Repair and Mutagenesis; ASM Press: Washington, DC, USA, 2006; pp. 92–107. [Google Scholar]
- Ravanat, J.L.; Douki, T.; Cadet, J. Direct and indirect effects of UV radiation on DNA and its components. J. Photochem. Photobiol. B Biol. 2001, 63, 88–102. [Google Scholar] [CrossRef]
- Otake, M.; Yoshikawa, K.O.; Yamaguchi, H.; Hidema, J. 222 nm ultraviolet radiation C causes more severe damage to guard cells and epidermal cells of Arabidopsis plants than does 254 nm ultraviolet radiation. Photochem. Photobiol. Sci. 2021, 20, 1675–1683. [Google Scholar] [CrossRef]
- Hale, G.M.; Querry, M.R. Optical constants of water in the 200-nm to 200-µm wavelength region. Appl. Opt. 1973, 12, 555–563. [Google Scholar] [CrossRef]
- Daimon, M.; Masumura, A. Measurement of the refractive index of distilled water from the near-infrared region to the ultraviolet region. Appl. Opt. 2007, 46, 3811–3820. [Google Scholar] [CrossRef]
- Smith, R.C.; Baker, K.S. Optical properties of the clearest natural waters (200–800 nm). Appl. Opt. 1981, 20, 177–184. [Google Scholar] [CrossRef]
- Quickenden, T.I.; Irvin, J.A. The ultraviolet absorption spectrum of liquid water. J. Chem. Phys. 1980, 72, 4416–4428. [Google Scholar] [CrossRef]
- Refractive Index Database. Available online: https://refractiveindex.info/ (accessed on 15 October 2021).
- Taniyasu, Y.; Kasu, M.; Makimoto, M. An aluminium nitride light-emitting diode with a wavelength of 210 nanometres. Nature 2006, 441, 325–328. [Google Scholar] [CrossRef] [PubMed]
- Matsumoto, T.; Iwayama, S.; Saito, T.; Kawakami, Y.; Kubo, F.; Amano, H. Handheld Deep Ultraviolet Emission Device Based on Aluminum Nitride Quantum Wells and Graphene Nanoneedle Field Emitters. Opt. Express 2012, 20, 24320–24329. [Google Scholar] [CrossRef] [PubMed]
- Hayashi, T.; Kawase, Y.; Nagata, N.; Senga, T.; Iwayama, S.; Iwaya, M.; Takeuchi, T.; Kamiyama, S.; Akasaki, I.; Matsumoto, T. Demonstration of Electron Beam Laser Excitation in the UV Range using a GaN/AlGaN Multiquantum Well Active Layer. Sci. Rep. 2017, 7, 2944. [Google Scholar] [CrossRef] [Green Version]
- Hecht, E. Optics, 5th ed.; Pearson Education, Ltd.: Boston, MA, USA, 2017. [Google Scholar]
- Bolton, J.R.; Linden, K.G. Standardization of methods for fluence (UV dose) determination in bench-scale UV experiments. J. Environ. Eng. 2003, 129, 209–216. [Google Scholar] [CrossRef]
- Bolton, J.R.; Beck, S.E.; Linden, K.G. Protocol for the Determination of Fluence (UV Dose) Using A Low-Pressure or Low-Pressure High-Output UV Lamp in Bench-Scale Collimated Beam Ultraviolet Experiments. IUVA News 2015, 17, 11–16. [Google Scholar]
- Kohmura, Y.; Igami, N.; Tatsuno, I.; Hasegawa, T.; Matsumoto, T. Transient photothermal inactivation of Escherichia coli stained with visible dyes by using a nanosecond pulsed laser. Sci. Rep. 2020, 10, 17805. [Google Scholar] [CrossRef]
- Chen, R.Z.; Craik, S.A.; Bolton, J.R. Comparison of the action spectra and relative DNA absorbance spectra of microorganisms: Information important for the determination of germicidal fluence (UV dose) in an ultraviolet disinfection of water. Water Res. 2009, 43, 5087–5096. [Google Scholar] [CrossRef]
- Tatsuno, I.; Niimi, Y.; Tomita, M.; Terashima, H.; Hasegawa, T.; Matsumoto, T. Mechanism of transient photothermal inactivation of bacteria using a wavelength-tunable nanosecond pulsed laser. Sci. Rep. 2021, 11, 22310. [Google Scholar] [CrossRef]
- Inagaki, T.; Hamm, R.N.; Arakawa, E.T. Optical and dielectric properties of DNA in the extreme ultraviolet. J. Chem. Phys. 1974, 61, 4246–4250. [Google Scholar] [CrossRef]
- Linden, K.G.; Shin, G.; Sobsey, M.D. Comparative effectiveness of UV wavelengths for the inactivation of Cryptosporidium parvum oocysts in water. Water Sci. Technol. 2001, 43, 171–174. [Google Scholar] [CrossRef]
- Cabaj, A.; Sommer, R.; Pribil, W.; Haider, T. The spectral UV sensitivity of microorganisms used in biodosimetry. Water Supply 2002, 2, 175–181. [Google Scholar] [CrossRef]
- Mamane-Gravetz, H.; Linden, K.G.; Cabaj, A.; Sommer, R. Spectral Sensitivity of Bacillus subtilis Spores and MS2 Coliphage for Validation Testing of Ultraviolet Reactors for Water Disinfection. Environ. Sci. Technol. 2005, 39, 7845–7852. [Google Scholar] [CrossRef] [PubMed]
- Shimoda, H.; Matsuda, J.; Iwasaki, T.; Hayasaka, D. Efficacy of 265-nm ultraviolet light in inactivating infectious SARS-CoV-2. J. Photochem. Photobiol. 2021, 7, 100050. [Google Scholar] [CrossRef] [PubMed]
- Pirnie, M.; Linden, K.G.; Malley., J.P. Ultraviolet Disinfection Guidance Manual for the Final Long Term 2 Enhanced Surface Water Treatment Rule; EPA 815-R-06-007; U.S. Environmental Protection Agency, Office of Water: Washington, DC, USA, 2006.
- Nardell, E.A.; Bucher, S.J.; Brickner, P.W.; Wang, C.; Vincent, R.L.; Becan-McBride, K.; James, M.A.; Michael, M.; Wright, J.D. Safety of upper-room ultraviolet germicidal air disinfection for room occupants: Results from the tuberculosis ultraviolet shelter study. Public Health Rep. 2008, 123, 52–60. [Google Scholar] [CrossRef] [PubMed] [Green Version]
- Rakić, A.D. Algorithm for the determination of intrinsic optical constants of metal films: Application to aluminum. Appl. Opt. 1995, 34, 4755–4767. [Google Scholar] [CrossRef]
- Johnson, P.B.; Christy, R.W. Optical constants of transition metals: Ti, V, Cr, Mn, Fe, Co, Ni, and Pd. Phys. Rev. B 1974, 9, 5056–5070. [Google Scholar] [CrossRef]
- Hsu, T.-C.; Teng, Y.-T.; Yeh, Y.-W.; Fan, X.; Chu, K.-H.; Lin, S.-H.; Yeh, K.-K.; Lee, P.-T.; Lin, Y.; Chen, Z.; et al. Perspectives on UVC LED: Its Progress and Application. Photonics 2021, 8, 196. [Google Scholar] [CrossRef]
- Oto, T.; Banal, R.G.; Kataoka, K.; Funato, M.; Kawakami, Y. 100 mW deep-ultraviolet emission from aluminium-nitride-based quantum wells pumped by an electron beam. Nat. Photonics 2010, 4, 767–770. [Google Scholar] [CrossRef]
- Matsumoto, T.; Mimura, H. Intense electron emission from graphite nanocraters and their application to time-resolved x-ray radiography. Appl. Phys. Lett. 2004, 84, 1804–1806. [Google Scholar] [CrossRef]
- Matsumoto, T.; Neo, Y.; Mimura, H.; Tomita, M.; Minami, N. Stabilization of electron emission from nanoneedles with two dimensional graphene sheet structure in a high residual pressure region. Appl. Phys. Lett. 2007, 90, 103516. [Google Scholar] [CrossRef]
- Matsumoto, T.; Neo, Y.; Mimura, H.; Tomita, M. Determining the physisorption energies of molecules on graphene nanostructures by measuring the stochastic emission-current fluctuation. Phys. Rev. E 2008, 77, 031611. [Google Scholar] [CrossRef] [PubMed]
- Gerba, C.P.; Gramos, D.M.; Nwachuku, N. Comparative inactivation of enteroviruses and adenovirus 2 by UV light. Appl. Environ. Microbiol. 2002, 68, 5167–5169. [Google Scholar] [CrossRef] [PubMed] [Green Version]
- Chatterley, C.; Linden, K. Demonstration and evaluation of germicidal UV-LEDs for point-of-use water disinfection. J. Water Health 2010, 8, 479–486. [Google Scholar] [CrossRef] [PubMed] [Green Version]

| Wavelength (nm) | E. coli O1 | P. aeruginosa | S. epidermidis | E. coli DH5α |
|---|---|---|---|---|
| 200 | 0.1 | 0.1 | 0.07 | 0.25 |
| 220 | 0.15 | 0.22 | 0.38 | 1.2 |
| 240 | 0.17 | 0.2 | 0.39 | 1.3 |
| 260 | 0.6 | 0.7 | 0.81 | 3.2 |
| 280 | 0.4 | 0.4 | 0.51 | 2.3 |
| 300 | 0.06 | 0.05 | 0.1 | 0.4 |
Publisher’s Note: MDPI stays neutral with regard to jurisdictional claims in published maps and institutional affiliations. |
© 2022 by the authors. Licensee MDPI, Basel, Switzerland. This article is an open access article distributed under the terms and conditions of the Creative Commons Attribution (CC BY) license (https://creativecommons.org/licenses/by/4.0/).
Share and Cite
Matsumoto, T.; Hoshiai, T.; Tatsuno, I.; Hasegawa, T. Action Spectra of Bacteria and Purification of Pollutant Water at Faucets Using a Water Waveguide Method. Water 2022, 14, 1394. https://doi.org/10.3390/w14091394
Matsumoto T, Hoshiai T, Tatsuno I, Hasegawa T. Action Spectra of Bacteria and Purification of Pollutant Water at Faucets Using a Water Waveguide Method. Water. 2022; 14(9):1394. https://doi.org/10.3390/w14091394
Chicago/Turabian StyleMatsumoto, Takahiro, Tsuyoshi Hoshiai, Ichiro Tatsuno, and Tadao Hasegawa. 2022. "Action Spectra of Bacteria and Purification of Pollutant Water at Faucets Using a Water Waveguide Method" Water 14, no. 9: 1394. https://doi.org/10.3390/w14091394
APA StyleMatsumoto, T., Hoshiai, T., Tatsuno, I., & Hasegawa, T. (2022). Action Spectra of Bacteria and Purification of Pollutant Water at Faucets Using a Water Waveguide Method. Water, 14(9), 1394. https://doi.org/10.3390/w14091394





